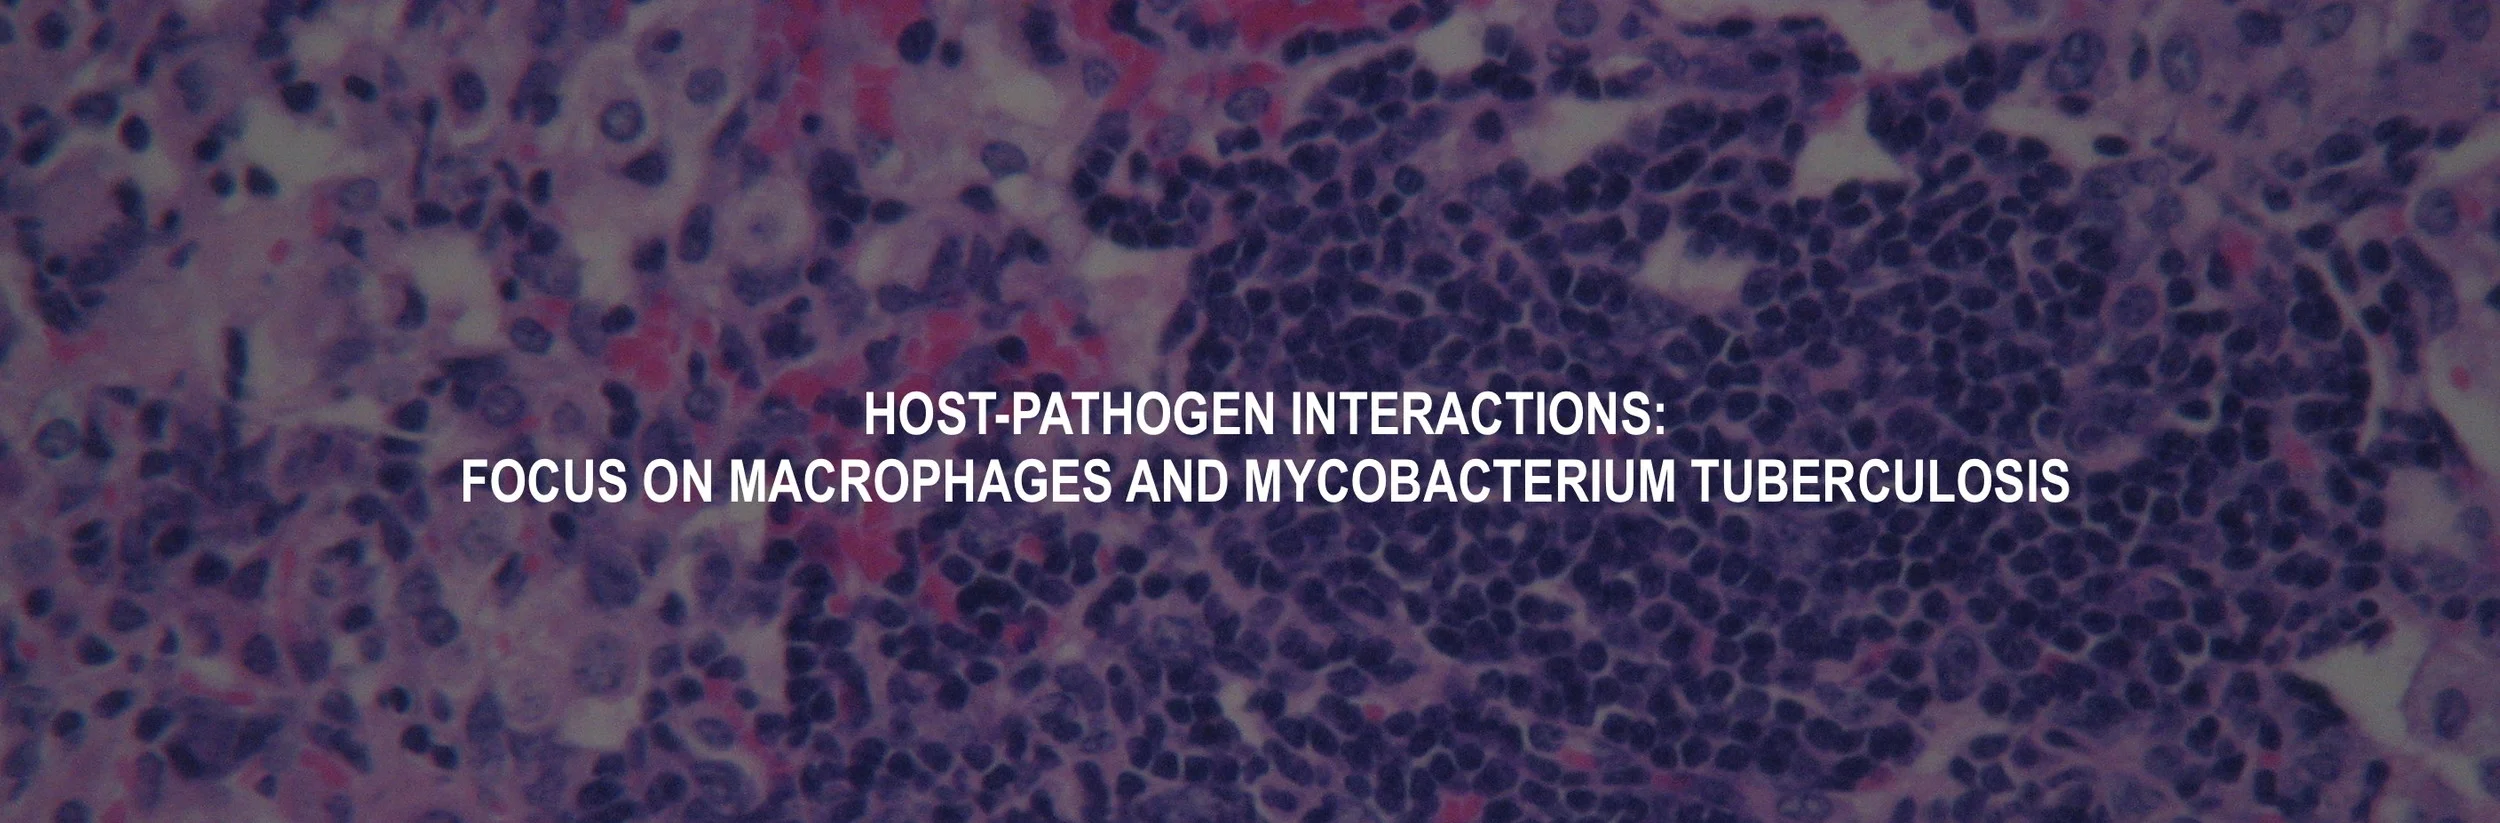

To better understand and improve how the immune system kills antigen, we focus on M. tuberculosis (Mtb) and the host’s interaction with it. There are two reasons for this choice. First, Mtb is one of a small number of pathogens that live almost exclusively in humans. This means that Mtb has evolved both to withstand and to exploit human immunity, about which it must have a great deal to teach us. Second, in recent years Mtb has been the leading cause of death from a single infectious agent until COVID-19 claimed that distinction. This is despite tuberculosis being a disease that was routinely curable. Today a growing number of cases are becoming incurable because of drug resistance. Juxtaposed, these facts speak of urgent medical need and the failure of conventional approaches to how drugs are discovered and deployed.
To the immunologist, Mtb presents a paradox that should be highly informative. Mtb typically elicits what is perhaps the most robust and well-rounded immune response of any known pathogen, yet avoids elimination by a large proportion of the people it infects. Host immunity drives the tissue pathology that sends Mtb forth in infectious droplets from the coughing, sneezing or talking host. Yet to spread the disease, Mtb must survive the immune response that was powerful enough to liquefy lung and then to survive the abrupt transitions in state that accompany aerosolization and inhalation.
Our efforts to understand Mtb’s persistence in the face of host immunity have revealed multiple layers of the bacterium’s defense: suppression of selective aspects of host immunity; catabolism of toxic host molecules; repair of the damage that host immune chemistries inflict on the bacterium; degradation of bacterial macromolecules too damaged to be repaired; sequestration of macromolecules too damaged to be degraded; and a program of replication delay that masquerades as cell death while the bacillus repairs or replaces oxidatively damaged macromolecules. We seek bacterial enzymes that mediate these processes and small molecules that inhibit those enzymes. Such compounds complement genetic and biochemical approaches for characterizing the functional significance of these resistance pathways and assessing their relevance for drug development.
Mycobacterium smegmatis expressing ClpB-dendra2 before (left) and after (right) exposure to a sublethal kanamycin. ClpB sequesters damaged macromolecules (Vaubourgeix et al., CHM 117: 179, 2015)